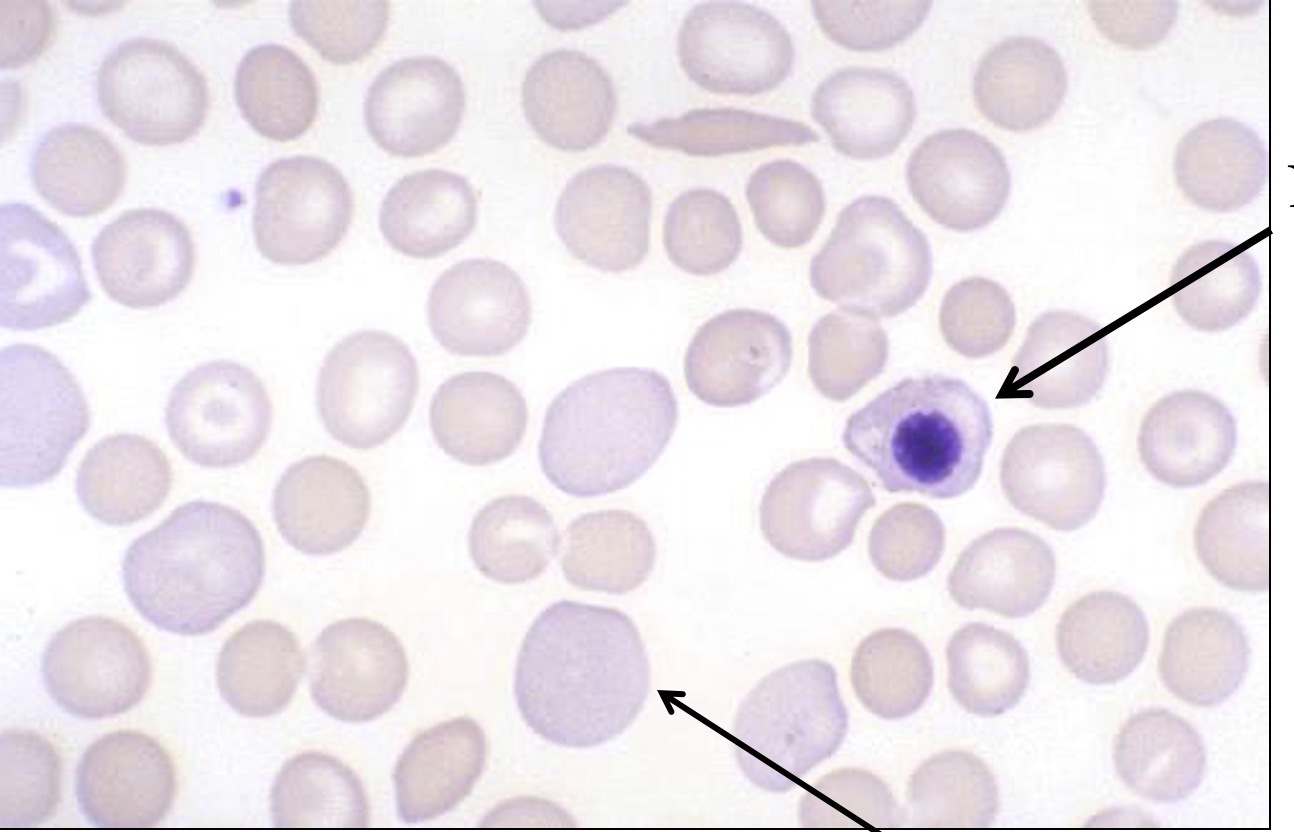
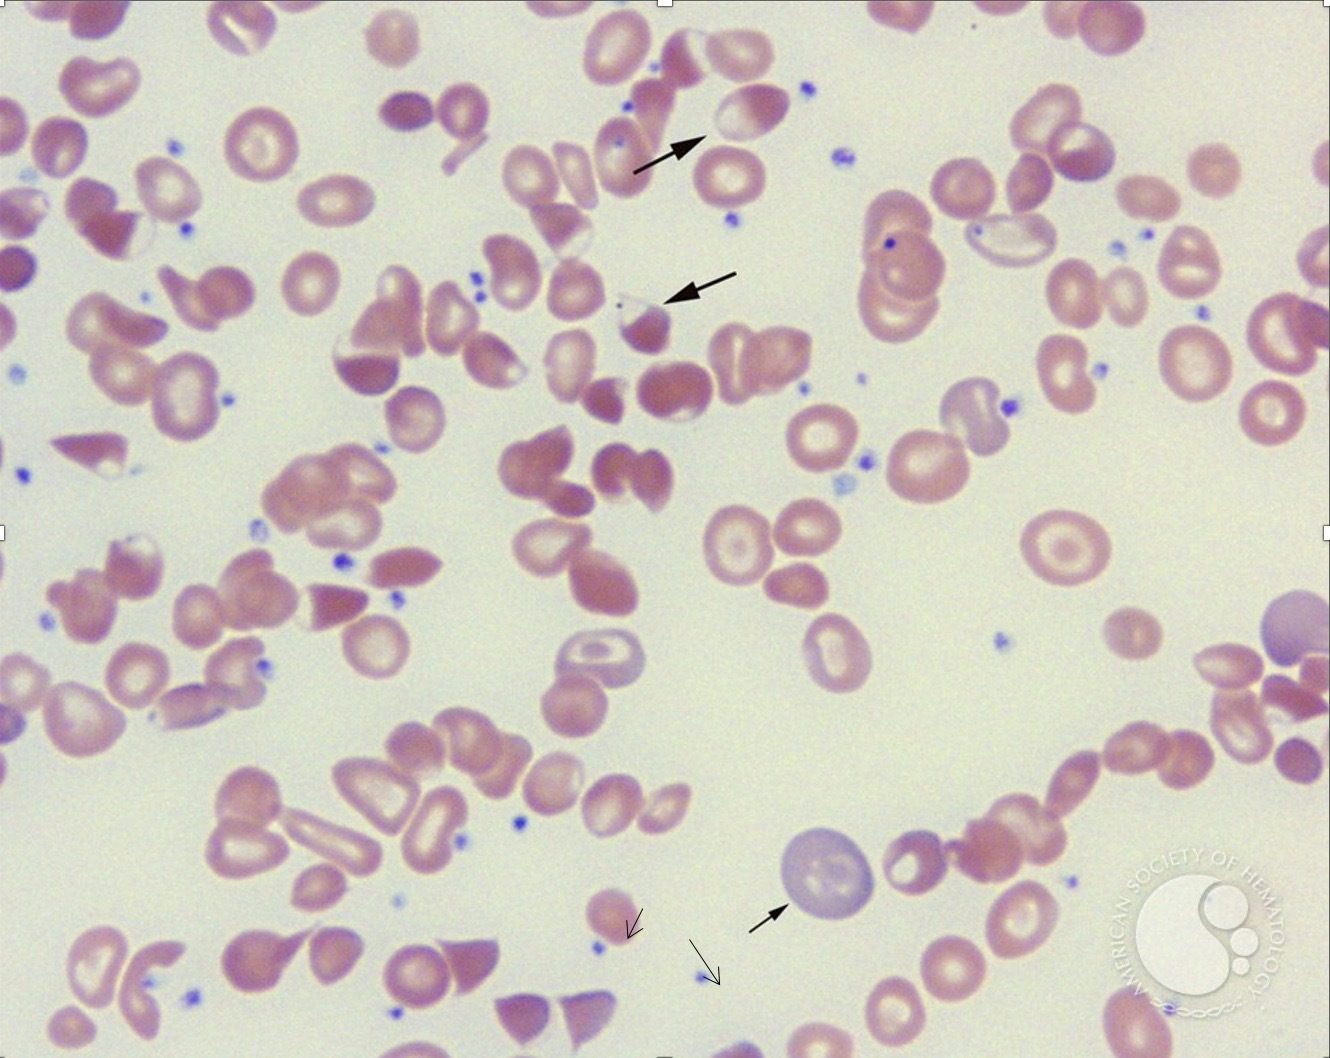
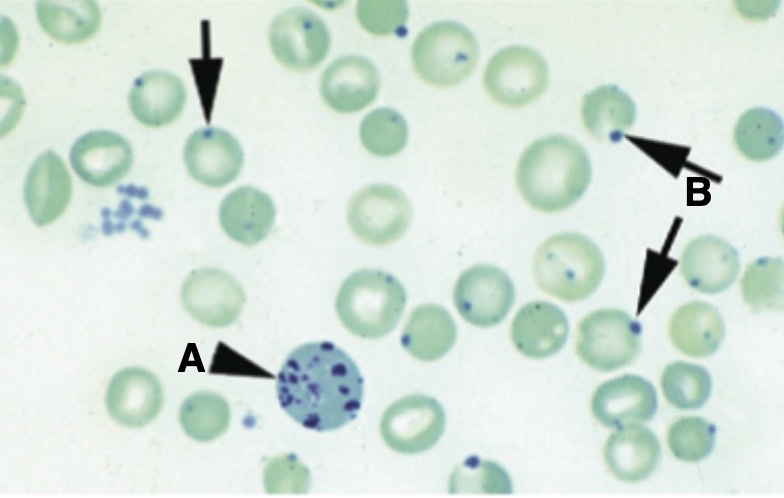
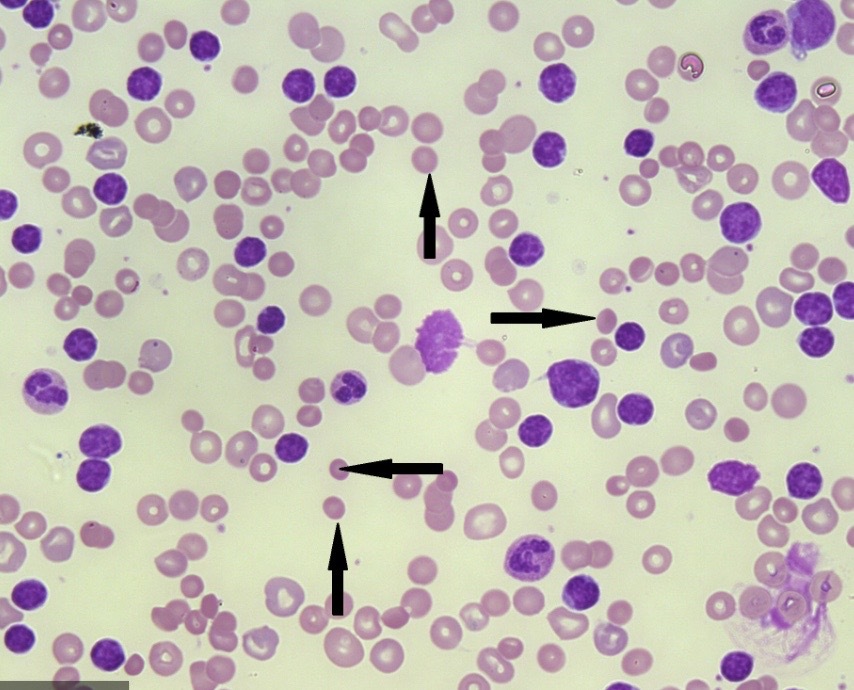
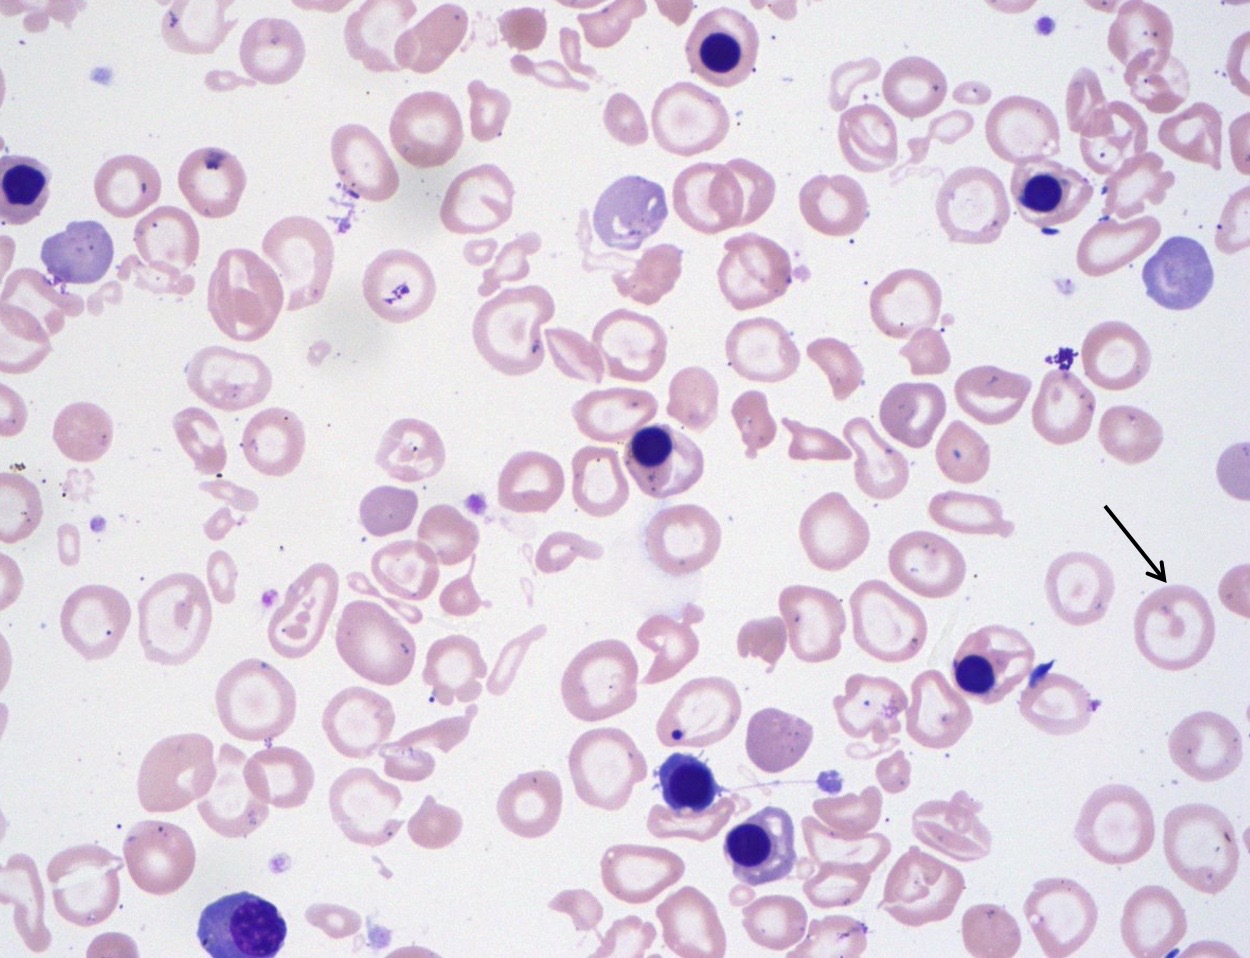
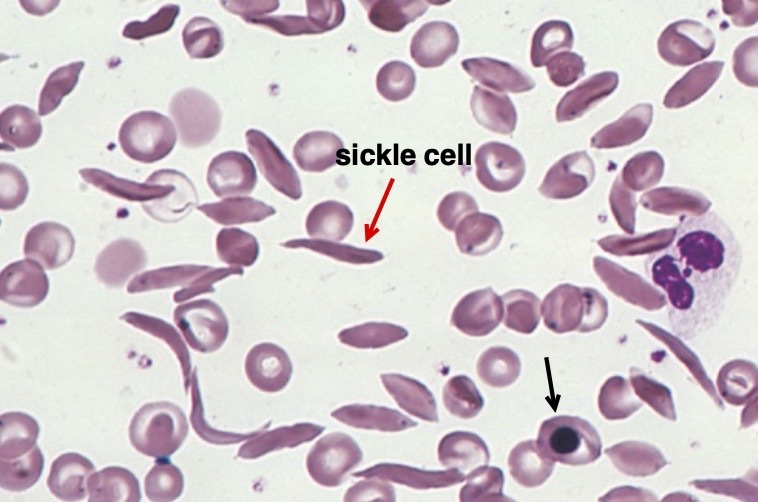
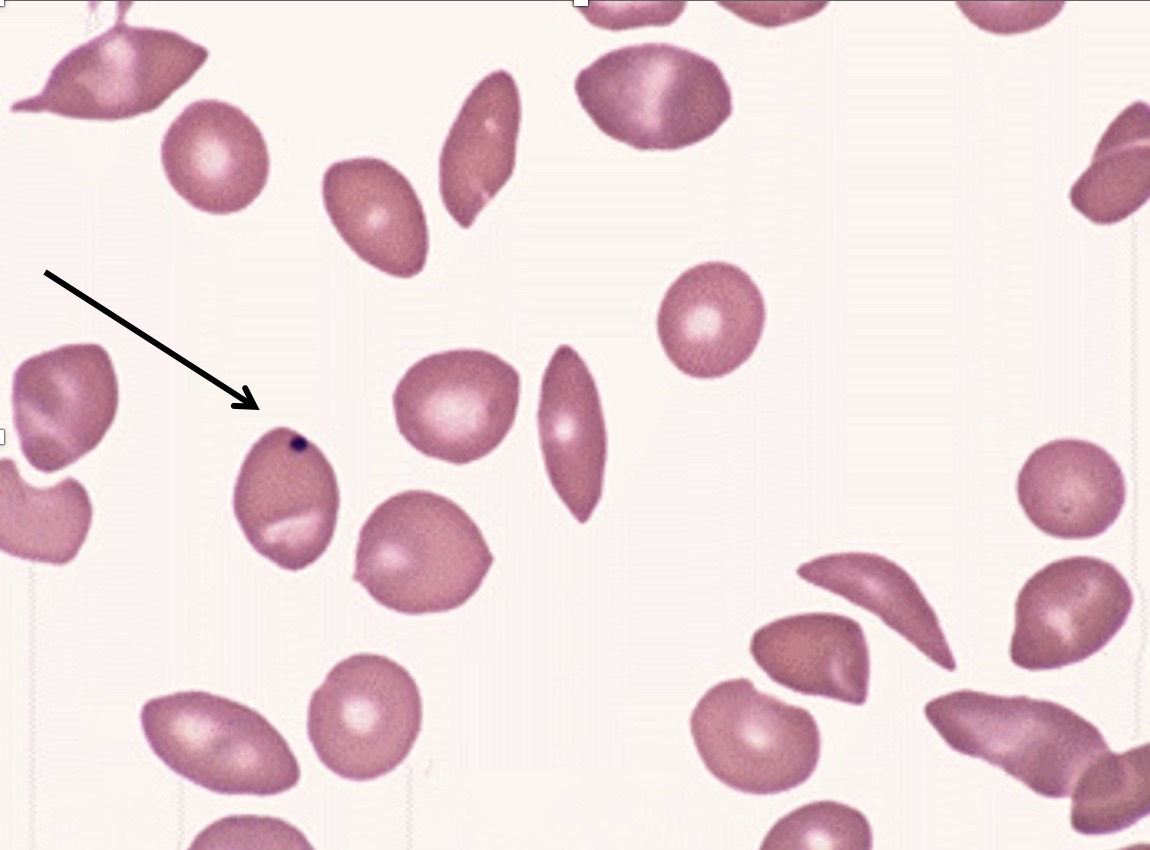

most common HA clinical picture
- pallor , jaundice , splenomegaly
in the blood smear shown
the upper arrow is representing
Nucleated RBC
in the blood smear shown
the lower arrow is representing

polychromatic macrocytic RBCs
in blood smear showed below
the first upper arrow is indicating

blister cells
in blood smear showed below
the last ( lowest to the left ) arrow is indicating
bite cells
stain used

methylene blue
what is A
reticulocyte
what are B

Heinz bodies
levels of bilirubin in G6PD def.
Increased
levels of LDH in G6PD def.
INCREASED
levels of HEPATOGLOBIN in G6PD def.
low
coombs test results in G6PD def.
Negative
test to be done to confirm G6PD def. Diagnosis
G6PD assay
Identify the cells pointed at by the arrow
spherocytes
Identify this lab test don in spherocytosis

Osmotic fragility test
levels of HbF in beta thalassemia major
high , > 80%
Levels of HbA2 in beta thalssemia minor
4-8%
levels of iron , ferritin , transferrin saturation in beta thalassemia minor
normal levels
blood smear of a Hb Bart’s hydrops fetalis syndrome
Identify the cells pointed by the arrow
target cells
mention the stain used

Brilliant cresyl blue
black arrow is showing
Nucleated RBC
Sickle cell anemia blood smear below ,
black arrow is showing
howell- jolly body
levels of HbF in sickle cells anemia
Increased
levels of HbA2 in sickle cell anemia
normal




